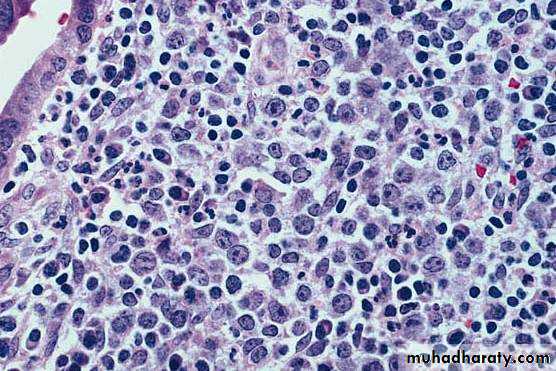
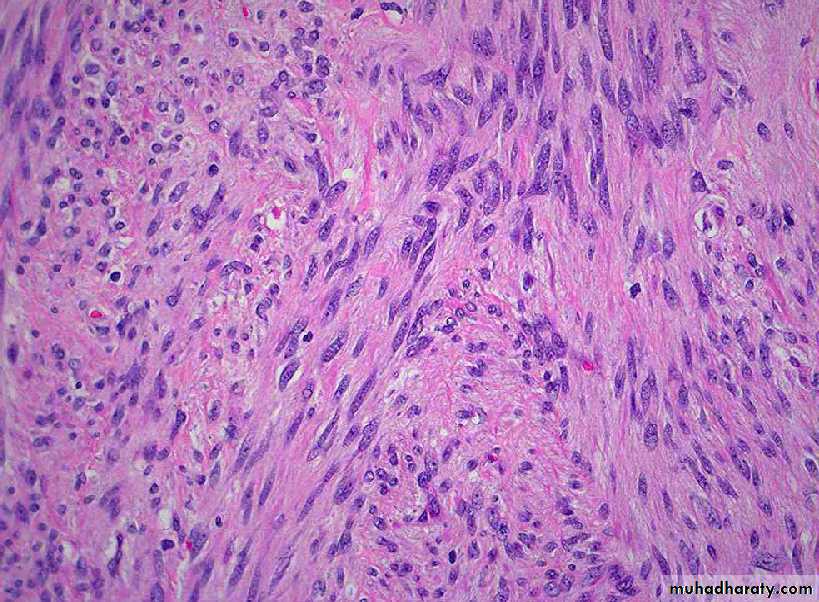

09888888;r
Pathology ofTHE FEMALE GENITAL TRACT
Dr. ISSRAA ALI HUSSEINour objectives are :
To understand some of the more common non-neoplastic vulvar, vaginal and cervical lesionsDiscussion of the more common forms of malignant tumors of the vulva ,vagina and cervix.
Details of CIN and cervical carcinoma regarding risk factors ,screening tests(Pap smear) ,and pathological findings .
Neoplasms OF THE VULVA
VULVAVULVITIS
What are The most important infectious agents?
●Human papillomavirus (HPV), causing:
■Condylomata acuminata.
■Vulvar intraepithelial neoplasia.
●Herpes simplex genitalis (HSV 1 or 2), causing:
■Vesicular eruption.
●Gonococci, causing :
Suppurative infection of the vulvovaginal glands.
VULVITIS
Contact Dermatitis is one of the most common causes of vulvar pruritus. It presents as erythematous weeping and crusting papules and plaques. Causes include urine, soaps, detergents, deodorants, etc.
TUMORS
1. Condylomas and Low-Grade Vulvar Intraepithelial Neoplasia (VIN)There are two biologic forms of anogenital warts (condylomas)
a. Condylomata lata: are manifestations of secondary syphilis & are flat, and slightly elevated.
b. Condylomata accuminata: are viral (HPV) warts and appear as elevated warty or flat & wrinkled localized lesions. They are often multiple, red-pink lesions that measure up to several centimeters in diameter.
Condylomata accuminata of the vulva
These appear as elevated warty localized lesions. They are often multiple, red-pink lesions that measure up to several centimeters in diameter
Microscopically
There is acanthosis and hyper/parakeratosis, with koilocytosis.Koilocytes are squamous cells with perinuclear cytoplasmic vacuoles and nuclear angulation.
The koilocytes are characteristic of HPV infection.
Indeed, VIN I and condylomas are both related to HPV 6 & 11 infections.
There is thickening of the epidermis (acanthosis), hyper/parakeratosis, and cytoplasmic vacuolation (koilocytosis, center).
Condyloma acuminatum
2. High-Grade VIN and Carcinoma of the Vulva
Carcinoma of the vulva is used to be seen mostly in elderly women.The vast majority of vulvar carcinomas are of squamous type.
The cancer was treated by radical vulvectomy. Squamous cell carcinoma of the vulva usually occurs in older women, or as a complication of HPV infection in younger women.Exophytic Squamous Cell Carcinoma arising from Rt. labium minus
Variably sized, invasive, squamous nests some with central keratinization.
Well-differentiated SCC of vulvaNeoplasms OF THE VAGINA
Vaginitis relatively a common problem that produces a vaginal discharge (leukorrhea).Many of the offenders are commensals that become pathogenic in conditions such as diabetes, antibiotic abuse, after abortion or pregnancy, or in AIDS.
Gonorrheal vaginitis may be transmitted to the newborn of the infected mother.
Nonspecific atrophic vaginitis
common cause of postmenopausal bleeding.It is associated with thinning (atrophy) of the squamous vaginal mucosa.
It is due to lack of estrogenic support of the vaginal epithelium.Malignant Tumors of Vagina
1. Squamous cell carcinoma is rare & usually occurs in elderly women, with risk factors similar to those for cervical carcinoma. Vaginal intraepithelial neoplasia is a precursor lesion associated with HPV infection.
2. Sarcoma botryoides (embryonal rhabdomyosarcoma), produces soft polypoid masses and is usually seen in infants and children younger than 5 years old.
Sarcoma botrryoides (embryonal rhabdomyosarcoma) of the vagina: Note the grape like configuration of the tumor
Neoplasms OF THE CERVIX UTERI
Cervicitis is a very common condition.Cytologic examination of the associated mucopurulent discharge reveals inflammatory cells admixed with cervical epithelial cells, and possible microorganisms.
It is often due to vaginal flora, streptococci, staphylococci, and E. coli.
Much more important are Chlamydia trachomatis, Ureaplasma, Trich. vaginalis, Candida spp., Neisseria gonorrhoeae, herpes simplex II (genitalis), and HPV.
Many of these microorganisms are transmitted sexually.
Herpetic infections of the cervix may be transmitted to the infant during its passage through the birth canal, resulting sometimes in a serious fatal systemic infection.
Cervical Tumors
Despite dramatic improvements in early diagnosis and treatment, cervical carcinoma continues to be one of the major causes of cancer-related deaths in women in the developing world.Cervical Intraepithelial Neoplasia (CIN)
Nearly all invasive cervical squamous cell carcinomas arise from precursor epithelial changes referred to as cervical intraepithelial neoplasia (CIN).
The Pap smear, introduced 50 years ago by Papanicolaou, remains the most successful cancer screening test ever developed.
Cytological examination can detect CIN long before any abnormality can be seen grossly.
Detection of CIN by the Pap smear at an early stage permits curative treatment.
In populations that are screened regularly, cervical cancer mortality is reduced by up to 99%.CIN begins as low-grade lesion that may progress to higher grade CIN, or it is a high-grade lesions from the outset.
This depends on the location of the HPV infection in the transformation zone, the type of HPV infection , and other host factors.
CIN I is characterized by koilocytotic changes (nuclear hyperchromasia and angulation with perinuclear vacuolization produced by cytopathic effect of HPV) in the superficial layers of the epithelium.
The dysplastic epithelium is limited to the lower third of the mucosa.
CIN II: the dysplasia is more severe, involving the lower two-thirds of the mucosa. The superficial layer in some cases shows the koilocytotic changes.
CIN III shows dysplastic changes that affect virtually all layers of the epithelium. Koilocytotic changes are usually absent.
Microscopic features CIN & Carcinoma in situ
On the basis of histology, precancerous changes are graded as:
CIN I: Mild dysplasiaCIN II: Moderate dysplasia
CIN III: Severe dysplasia/carcinoma in situ
The current Bethesda system divides the precancerous lesions into only two groups:
1. Low-grade SIL (SIL for squamous intraepithelial lesions), equivalent to CIN I
2. High-grade SIL. Equivalent to CIN II & III
Progression from low- to high-grade SIL may or may not occur.
The higher the grade of CIN the greater the likelihood of progression to invasive carcinoma, this reaches to 70% with CIN III.
Epidemiology and Pathogenesis
The peak age of CIN incidence is about 30 years.whereas that of invasive carcinoma is about 45 years i.e. precancerous changes usually take many years to evolve into overt carcinomas.
Important risk factors for the development of CIN and invasive carcinoma are:
1. Early age at first intercourse2. Multiple sexual partners
3. Persistent infection by "high-risk" papilloma viruses
4. Low socio-economic status
(All of the above favor a sexually transmitted causative agent HPV).
Indeed, HPV can be detected by molecular techniques in nearly all precancerous and cancerous lesions.
Specifically, high-risk HPV types including 16 & 18, account for the majority of cervical carcinomas.
By contrast, condylomas, which are benign lesions, are caused by low-risk HPV types (i.e., 6 & 11). In these benign lesions the viral DNA does not integrate into the host genome.
By contrast, HPV types 16 & 18 usually integrate into the host genome causing inactivation of the tumor suppressor genes p53 and RB, resulting in a transformed cell, capable of autonomous growth and susceptible to the acquisition of further mutations (cancer progression).
A recently introduced HPV vaccine is effective in preventing HPV infections and hence cervical cancers.
A cervical biopsy is performed after an abnormal
Pap smear result is obtained on a 42-year-old female. The biopsy shows that dysplastic cells occupy the full thickness of the epithelium above the basement membrane. A cervical conization is performed becauseShe has a high risk for invasive carcinoma.
HPV infection cannot be treated.She is perimenopausal
CIN I is present.
She has invasive cancer.
In time, dysplastic changes become more atypical and may extend into the endocervical glands, but the alterations are confined to the epithelial layer and its glands. These changes constitute carcinoma in situ.
The next stage is invasive canrcinoma.
The above progression sequences do not occur in all the cases.
Cervical cytology and cervical colposcopy remain the basis of cervical cancer prevention.
Invasive Carcinoma of the Cervix
The most common cervical carcinomas are (in descending order)
1. Squamous cell carcinomas (75%)
2. Adenocarcinomas and adenosquamous carcinomas (20%)
3. Small-cell neuroendocrine carcinomas (<5%).
The squamous cell carcinomas are increasingly appearing in younger women, (peak incidence at about 45 years); 10 to 15 years after detection of their precursors (CIN).
Invasive carcinomas of the cervix develop in the region of the transformation zone (the squamo-columnar junction) and range from invisible microscopic foci of early stromal invasion to grossly visible exophytic ulcerating masses or deeply infiltrative cancer that encircle the os.
A fungating ulcerative tumor that involves the cervix circumferentially
Advanced Carcinoma of the cervixa large, polypoid lesion present within the ectocervix. The mass appears hemorrhagic.
Squamous cell carcinoma of the cervix uteriA large cervical squamous cell Ca which spread to the vagina.
Advanced Cervical Carcinoma
Pelvic exenteration done for stage IV cervical Ca. The tumor has involved the cervix (centre), extended into the vagina and the UB anteriorlu. The vulva (below) and rectum and anus (posteriorly) can be seen.
Three microscopic variants of cervical SCC squamous cell carcinoma exist, although admixtures and intermediate forms occur:
1. Large cell nonkeratinizing
2. Keratinizing3. Small cell; this should be distinguished from small cell neuroendocrine carcinoma
nests of neoplastic squamous cells are invaded through a chronically inflamed stroma. This
cancer is well- differentiated, as evidenced by keratin pearls. However, most cervical squamous carcinomas are non-Keratinizing.
Squamous cell ca WD keratinizing
Distant metastases,including
para-aortic nodal involvement,remote organ involvement,
or invasion of adjacent structures such as bladder or rectum, occur late in the course of disease.
Spread to pelvic lymph nodes and organs correlates with tumor depth of invasion, ranging from 1-4
Conclusion
high-risk HPV types including 16 & 18, account for the majority of cervical carcinomas.By contrast, condylomas, which are benign lesions, are caused by low-risk HPV types (i.e., 6 & 11).
Detection of CIN by the Pap smear at an early stage permits curative treatment.
In populations that are screened regularly, cervical cancer mortality is reduced by up to 99%.
Ideally cervical carcinomas should be diagnosed in the preinvasive phase; these appear as white areas on colposcopic examination after application of dilute acetic acid (Schiller test).
Such tumors call to attention by unexpected vaginal bleeding, leukorrhea, painful coitus (dyspareunia), and dysuria.
Thank you
BODY OF UTERUSEndometritis
This may be associated with retained products of conception subsequent to miscarriage or delivery, or a foreign body such as an intrauterine device.Retained tissues or foreign bodies act as a nidus for infection, frequently by flora ascending from the vaginal or anal region.
All forms of endometritis may present with menstrual abnormalities, infertility and ectopic pregnancy due to extension of the damaging inflammation to the fallopian tubes.
Acute endometritis is frequently due to N. gonorrhoeae or C. trachomatis.
There is a large number of plasma cells (arrows).
Chronic endometritisA 19-year-old female whose Pap smear demonstrates
many neutrophils but no dysplastic cells.
A cervical culture grows N. gonorrhoeoe. If this infection
is not adequately treated, the patient will be at increased
risk for
Ectopic pregnancy
Dysfunctional uterine bleeding
Cervical carcinoma
Endometrial hyperplasia
Endometriosis
Adenomyosis
This refers to the “invagination of the stratum basalis of endometrium down into the myometrium.” Nests of endometrial stroma, glands, or both, are found well down in the myometrium between the muscle bundles. The latter become hypertrophied.uterus is enlarged and globular.
Because these glands derive from the stratum basalis, they do not undergo cyclical bleeding. Nevertheless, marked adenomyosis may produce menorrhagia, dysmenorrhea, and pelvic pain before the onset of menstruation.
Adenomyosis uterus
Gross appearance of uterus involved by adenomyosis. The wall is irregularly thickened and contains small hemorrhagic foci (arrow).
The thickened and spongy appearing myometrial wall of this sectioned uterus is typical of adenomyosis. There is also a small white leiomyoma at the top
Adenomyosis of uterus
endometrial glands and stroma invaginated in myometriumEndometriosis
This is characterized by “the presence of endometrial glands and stroma in a location outside the endomyometrium.”It occurs in as many as 10% of women in their reproductive years and in nearly half of women with infertility.
It may present as a pelvic mass filled with degenerating blood (chocolate cyst).
It is frequently multifocal and may involve any tissue in the pelvis (ovaries, pouch of Douglas, uterine ligaments, tubes, and rectovaginal septum
Endometriosis. A, Endometriosis is present in the mucosa of the colon. B, Higher magnification reveals the presence of both endometrial glands and stroma
Three possibilities have been suugested to explain the origin of these lesions:-
1. The regurgitation theory, currently the most accepted, proposes menstrual backflow through the fallopian tubes with subsequent implantation.2. The metaplastic theory proposes endometrial differentiation of coelomic epithelium.
3. The vascular or lymphatic dissemination theory has been raised to explain extrapelvic endometriosis.
Endometriosis usually contains functioning endometrium, which undergoes cyclic bleeding, thus appearing grossly as red-blue to yellow-brown nodules, due to collected blood.
When the ovaries are involved, the lesions may form large, blood-filled cysts that are transformed into so-called chocolate cysts as the blood ages
Seepage and organization of the blood leads to widespread fibrosis, adherence of pelvic structures, sealing of the tubal fimbriated ends, and distortion of the oviducts and ovaries.
Endometriosis ovary
Inner surface of cyst in a case of ovarian endometriosis. The color is typically brown.
This is a section through an enlarnged 12 cm ovary to demonstrate a cystic cavity filled with old blood typical for endometriosis with formation of an endometriotic, or "chocolate", cyst.
Ovarianendometriosis In this area endometrial tissue faithfully reproduces the appearance of normal endometrium, in terms of both glands and stroma. Lt., collection of lipofuscin-laden histiocytes below the endometriotic epithelium.
Endometriosis ovary
Microscopic featuresThe histologic diagnosis depends on finding two of the following three features within the lesions:
1. Endometrial glands.
2. Endometrial stroma.
3. Hemosiderin pigment.
Extensive scarring of the oviducts and ovaries often causes sterility.
Pain on defecation reflects rectal wall involvement, and dyspareunia (painful intercourse) and dysuria reflect involvement of the uterine and bladder serosa, respectively.
In almost all cases, there is severe dysmenorrhea and pelvic pain as a result of intrapelvic bleeding and periuterine adhesions.
Dysfunctional Uterine Bleeding (DUB): is an abnormal bleeding in the absence of a well-defined organic lesion in the uterus.
Examples of the causes of DUB include :
Anovulatory cycles are very common at both ends or reproductive life, and have several cause including:
Endocrine dysfunctions e.g. of the hypothalamic-pituitary axis, adrenal, or thyroid
Ovarian lesions producing an excess of estrogen
Malnutrition, obesity, or debilitating diseaseSevere physical or emotional stress.
Regardless of the cause, an anovulatory cycle leads to an excess of estrogen relative to progesterone; the endometrial glands may appear crowded with mild cystic changes with a relative scant stroma.
The poorly supported endometrium partially collapses, with rupture of spiral arteries, accounting for the bleeding.
Endometrial glands appear crowded with mild cystic changes and a relative scant stroma.
The poorly supported endometrium partially collapses, with rupture of spiral arteries, accounting for the bleeding.Anovulatory (persistent proliferative) endometrium with stromal breakdown
Inadequate luteal phase. The corpus luteum may fail to mature normally or may regress prematurely, leading to a relative lack of progesterone. The endometrium under these circumstances shows delay in the development of the secretory changes expected at the date of biopsy.
Endometrial Hyperplasia
This is an exaggerated endometrial proliferation induced by sufficiently prolonged excess of estrogen relative to progestin.The severity of hyperplasia is classified according to two parameters
a. architectural crowding of the glands &
b. cytologic atypia.
Accordingly there are three categories
1. Simple hyperplasia
2. Complex hyperplasia
3. Atypical hyperplasia
These three categories represent a spectrum based on the level and duration of the estrogen excess.
The risk of developing carcinoma depends on the severity of the hyperplastic changes and associated cellular atypia.
Simple hyperplasia carries a negligible risk, while a woman with atypical hyperplasia has a 20% risk of developing endometrial carcinoma.
Thus When atypical hyperplasia is discovered, it must be carefully evaluated for the presence of cancer and must be monitored by repeated endometrial biopsy.
Any estrogen excess may lead to hyperplasia.
Potential contributors include1. Failure of ovulation, e.g. around the menopause
2. Prolonged administration of estrogenic steroids
3. Estrogen-producing ovarian lesions such as
a. polycystic ovaries (Stein-Leventhal syndrome)
4. Obesity, because adipose tissue processes steroid precursors into estrogens.
A 45-year-old female has had menorrhagia for the past 3 months. An endometrial biopsy shows a rather mild degree of endometrial hyperplasia. Which of the following conditions most likely helped to produce the findings in this case?
1-Ovarian mature cystic teratoma
2-Chronic endometritis
3-Failure of ovulation
4-Pregnancy
5-Use of oral contraceptives
Gross features
In simple hyperplasia the endometrium is diffusely thickenedIn complex & atypical hyperplasia there is usually focal thickening of the endometrium.
Microscopic features
Simple hyperplasia involves both the glands & stroma; the normal gland to stroma ratio is maintained. The glands are proliferative and some are cystically dilated.
Complex hyperplasia: there is glandular crowding with little stroma separating the proliferative glands. Typically, this is a focal process.
Simple and complex hyperplasias are further divided into atypical and non-atypical
Atypical hyperplasia: characterized by atypical nuclei of the proliferative glands as evidenced by nuclear stratification, nuclear rounding and the presence of nucleoli.
The prominent thickened folds of endometrium in this uterus (opened to reveal the endometrial cavity) are an example of hyperplasia.
Diffuse endometrial hyperplasia
Closely packed endometrial glands with irregular distribution, separated by abundant endometrial stroma (A). Glands are lined by proliferative-type endometrial epithelium without atypia (B).
Complex endometrial hyperplasia without atypia
Nuclear and cytoplasmic differences are present between atypical glands (upper Rt.) and residual normal endometrial glands (center).Atypical endometrial hyperplasia
Tumors of the Endometrium and Myometrium
The most common neoplasms of the body of the uterus are1. Endometrial polyps,
2. Smooth muscle tumors.
3. Endometrial carcinomas.
All tend to produce bleeding from the uterus as the earliest manifestation.
Endometrial polyp
Huge endometrial polyp filling the endometrial cavity. There is also a smaller endocervical polyp and a subserosal leiomyoma.
The uterus has been opened anteriorly through cervix and into the endometrial cavity. High in the fundus and projecting into the endometrial cavity is a small endometrial polyp. Such benign polyps may cause uterine bleeding.
Cystically dilated glands and a fibrous stroma with thick-walled vessels.
Endometrial polyp LP micLeiomyomas
Are benign tumors that arise from the smooth muscle cells in the myometrium.
Because of their firmness they are also called fibroids.
They are the most common benign tumor in females and are found in 30% to 50% of women during reproductive life.
Estrogens and possibly oral contraceptives stimulate their growth; conversely, they shrink postmenopausally.
Gross features
They are sharply circumscribed, firm gray-white masses with a characteristic whorled cut surface.They may occur singly, but are often multiple tumors scattered within the uterus, ranging in size from small seedings to massive neoplasms that dwarf the size of the uterus.
Some are embedded within the myometrium (intramural), whereas others may lie directly beneath the endometrium (submucosal) or directly beneath the serosa (subserosal).
Larger neoplasms may show foci of ischemic necrosis with areas of hemorrhage and cystic softening (red degeneration)
After menopause they may become densely collagenous and even calcified.
Markedly distorted uterine corpus with multiple irregular masses protruding from its surface. These are subserosal leiomyomata.
Leiomyomas uteri
The uterus has been opened revealing several large masses that protrude from under the endometrial mucosa (submucosal). There are also intramural and subserosal examples. One of the submucosal tumor is in the form of pedunculated polyp that has protruded through the cervix
Leiomyoma uterus gross
Multiple uterine leiomyomas.
Smooth muscle tumors of the uterus are often multiple. Seen here are submucosal, intramural, and subserosal leiomyomata of
the uterus.
Uterus, leiomyomata
Leiomyoma uterus gross
Microscopic featuresThere are whorling bundles of smooth muscle cells.
Foci of fibrosis, calcification, ischemic necrosis, cystic degeneration, and hemorrhage may be present.
Leiomyomas of the uterus may be entirely asymptomatic and be discovered only on routine pelvic examination or imaging studies.
The most frequent manifestation, when present, is menorrhagia.
Large masses in the pelvic region may become palpable or may produce a dragging sensation. Benign leiomyomas rarely transform into sarcomas.
Here is the microscopic appearance of a benign leiomyoma. Normal myometrium is at the left, and the neoplasm is well-differentiated so that the leiomyoma at the right hardly appears different. Bundles of smooth muscle are interlacing in the tumor mass.
Leiomyoma uteri
Leiomyoma uteri
Leiomyosarcomas
Typically arise de novo from the mesenchymal cells of the myometrium.They are almost always solitary tumors, in contradistinction to the frequently multiple leiomyomas.
Gross features
The tumor is typically bulky
It infiltrates the uterine wall.
Sometimes it projects into the endometrial cavity.
They are frequently soft, hemorrhagic, and necrotic.
Leiomyosarcoma uterus gross
The tumor forms a large , irregular intramural and submucous mass. There are foci of hemorrhage (red) and necrosis( yellow).
This is a leiomyosarcoma protruding from myometrium into the endometrial cavity of this uterus that has been opened sagittally so that the halves of the cervix appear at up and down. Fallopian tubes and ovaries project from both sides. The irregular nature of this mass suggests that is not just an ordinary leiomyoma.
Uterus, leiomyosarcoma, Gross
Microscopic features
They show a wide range of differentiation, from those that closely resemble leiomyoma to wildly anaplastic tumors.The diagnostic features of leiomyosarcoma include tumor necrosis, cytologic atypia, and mitotic activity.
Sometimes increased mitotic activity is seen in benign smooth muscle tumors in young women, thus assessment of all three features is needed to make a diagnosis of malignancy
Recurrence after removal is common with these cancers, and many metastasize, typically to the lungs.
The tumor is much more cellular and the cells have much more pleomorphism and hyperchromatism than the benign leiomyoma. An irregular mitosis is seen in the center.
Leiomyosarcoma
As with sarcomas in general, leiomyosarcomas have spindle cells. Several mitoses are seen here, just in this one high power field.
Leiomyosarcoma
Endometrial Carcinoma (EMC)
After the dramatic drop in the incidence of cervical carcinoma, EMC is currently the most frequent cancer occurring in the female genital tract.Epidemiology and Pathogenesis
EMC appears most frequently around the age of 60 years.
There are two clinico-pathological settings in which endometrial carcinomas arise:
1. In perimenopausal women with estrogen excess; these are of endometrioid type
2. In older women with endometrial atrophy; these are of serous type.
Well-defined risk factors for endometrioid carcinoma include
a. Obesity: associated with increased synthesis of estrogens in fat depotsb. Diabetes
c. Hypertension
d. Infertility: women tend to be nulliparous, often with anovulatory cycles.
At least some of these risk factors point to increased estrogen stimulation, and indeed it is well recognized that prolonged estrogen replacement therapy and estrogen-secreting ovarian tumors increase the risk of this form of cancer.
Gross features
EMC may be exophytic (fungating, polypoid) or infiltrative.Microscopic features
The endometrioid carcinoma consists of malignant endometrial-like tubular glands of varying grades. Squamous metaplasia is frequent. Sometimes, the tumor is adeno-squamous carcinoma.
Tumors originate in the mucosa and may infiltrate the myometrium and enter vascular spaces, with metastases to regional lymph nodes.
Serous carcinoma forms small tufts and papillary arrangements rather than the glands seen in endometrioid carcinoma, and has much greater cytologic atypia. They are particularly aggressive .
The tumor shown is polypoid (exophytic)
Endometrial adenocarcinomaThe tumor shown is extensive, nodular & highly infiltrating.
A, Endometrioid type, infiltrating myometrium and displaying cribriform architecture. B, Higher magnification reveals loss of polarity and nuclear atypia.Endometrioid adenocarcinoma
Endometrial adenocarcinoma of endometrioid type with acomponent of squamous carcinoma (arrow). In contrast to the previous figure, the squamous component has markedly atypical cytologic features.
Adenosquamous ca
C, displaying formation of papillae and marked cytologic atypia. D, Immunohistochemical stain for p53 reveals accumulation of mutant p53 in serous carcinoma.
Serous carcinoma of the endometrium
Patients with EMC presents with leukorrhea and irregular bleeding.
With progression, the uterus may become palpable, and in time it becomes fixed to surrounding structures by extension of the cancer beyond the uterus.EMCs are usually late-metastasizing neoplasms,
The prognosis depends heavily on the stage of the disease.